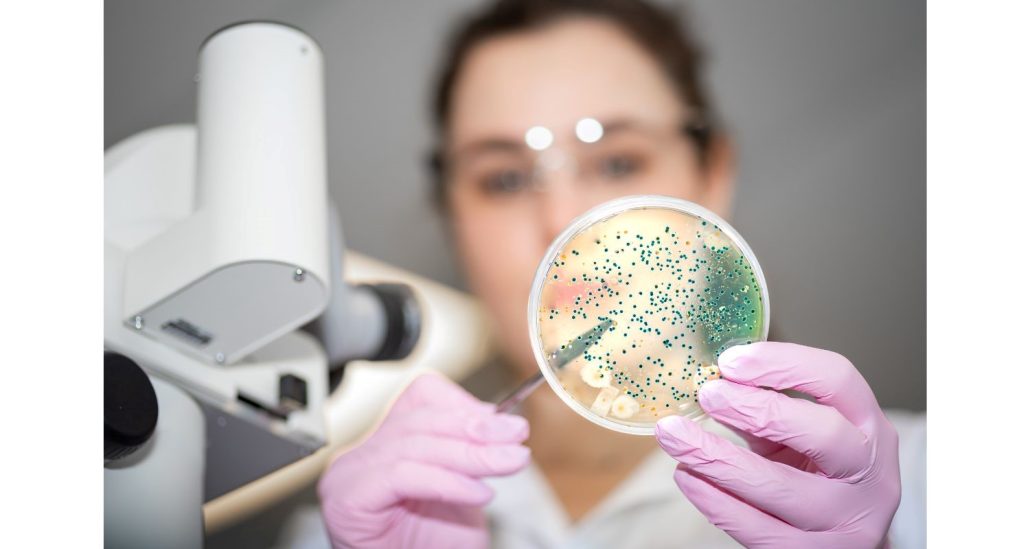
En Durviz ponemos a disposición de los investigadores diferentes soluciones diseñadas específicamente para el análisis del microbioma intestinal

A través del programa Nature Awards, la revista Nature abre convocatoria de becas para investigaciones que realizan trabajos sobre nutrición, microbioma intestinal y función de barrera. Se trata de unas ayudas con las que se quiere conocer cómo la nutrición modula el microbioma intestinal y la función de barrera que desempeña.
Nature abre convocatoria de becas para investigaciones sobre nutrición, microbioma intestinal y función de barrera
La comunidad científica continúa desvelando el papel que el microbioma intestinal desempeña en el mantenimiento de nuestra salud y en la prevención de enfermedades. Una aportación que se considera fundamental pero que requiere todavía de muchos estudios al respecto. En especial de la composición de las comunidades microbianas que habitan nuestro intestino. Una realidad que está estrechamente influenciada por la dieta y hace que estas bacterias impacten en funciones tan críticas como la integridad de la barrera intestinal, el metabolismo, el sistema inmune o, incluso, la salud mental.

Subvenciones Globales para la Salud Intestinal
En este contexto, el programa Global Grants for Gut Health (Subvenciones Globales para la Salud Intestinal), impulsado por Nature -una de las revistas científicas semanales internacionales más importantes de la actualidad-, ha abierto una nueva convocatoria de financiación para el año 2025 que profundice en el conocimiento del microbioma.
La convocatoria está destinada a apoyar investigaciones innovadoras que estudien cómo la nutrición modula el microbioma intestinal y la función de barrera. Este programa financiará hasta tres proyectos por ciclo, con ayudas de hasta 100.000 dólares estadounidenses cada uno.
Los proyectos seleccionados buscarán profundizar en el conocimiento sobre la interacción entre nutrientes, microbiota y la homeostasis de la barrera intestinal, con el objetivo de transformar nuestra comprensión de este complejo ecosistema microbiano y las implicaciones clínicas que tiene.
Las Subvenciones Globales para la Salud Intestinal son una iniciativa de financiación competitiva que apoya la investigación innovadora, liderada por investigadores, y que se centra en la microbiota intestinal humana. Busca impulsar la comprensión científica del papel crucial que desempeña el microbioma intestinal en la salud humana.
Durviz, apoyando la investigación del microbioma
Desde Durviz compartimos el entusiasmo de Nature por el avance en este apasionante campo de estudio. Por ello, ponemos a disposición de los investigadores diferentes soluciones diseñadas específicamente para analizar el microbioma intestinal, desde la toma de muestra hasta la obtención de ácidos nucleicos de alta calidad. Estos son:
- Kit de recolección y conservación de muestras fecales: Un kit que permite la recogida de muestras fecales y asegura la conservación de la composición del microbioma durante largos períodos de tiempo para su posterior análisis microbiológico o genético. Es decir, se trata de un sistema integrado que ha sido especialmente pensado para realizar la recolección, el transporte y el almacenamiento de muestras de heces para la posterior purificación de ADN. Un conjunto de elementos que hacen que el ADN estabilizado se pueda transportar en la solución de estabilización sin necesidad de refrigeración a temperatura ambiente. Lo que conlleva importantes ventajas.
- Kits de extracción y purificación de ácidos nucleicos de microbiota: Sistemas optimizados para obtener ADN y ARN microbiano de alta pureza y rendimiento, incluso a partir de matrices complejas como las heces, garantizando resultados fiables para secuenciación o análisis metagenómico. Ha sido diseñado para conseguir una purificación rápida y eficiente de ADN microbiano que permita realizar el análisis de microbioma a partir del homogeneizado de heces de 0,50-1,0 g, estabilizado en el kit de recolección de muestras de microbioma REAL STOOL de 8 ml. Para ello, en este procedimiento, los microorganismos se lisan eficientemente mediante una combinación de calor, disrupción química y mecánica con microesferas especializadas.
Tu investigación puede marcar la diferencia, y queremos ayudarte
En Durviz queremos que nuestro trabajo contribuya al avance científico. Sabemos que este tipo de herramientas que ofrecemos ayudan en este sentido. Que son clave para facilitar que los estudios alcancen altas cotas de calidad, que permitan explorar cómo los distintos componentes de la dieta alteran las comunidades microbianas, y cómo estos cambios pueden afectar la función de la barrera intestinal y a la salud global del individuo.
Por ello, si estás trabajando en un proyecto en este ámbito o planeas presentarte a la convocatoria de Nature, no dudes en contactarnos. Estaremos encantados de asesorarte en la elección de los kits y acerca de los protocolos más adecuados para el desarrollo de tu investigación.

